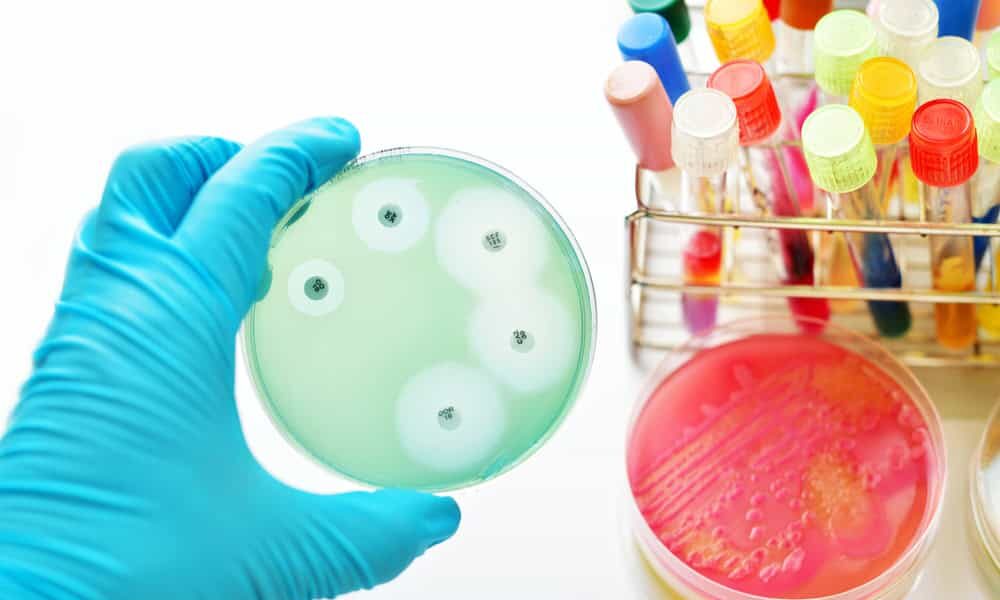

Για πρώτη φορά, Αμερικανοί ερευνητές βρήκαν ότι ο υγιής ιστός του στήθους περιέχει διαφορετικά μικρόβια, σε σχέση με τον ιστό ασθενών με καρκίνο του μαστού. Τα ευρήματα ανοίγουν το δρόμο για την ανάπτυξη νέων θεραπειών για τον πιο συχνό καρκίνο στις γυναίκες.
Μικρόβια που ζουν φυσιολογικά στον οργανισμό μας, γνωστό ως μικροβίωμα, επηρεάζουν πολλές ασθένειες. Το μεγαλύτερο μέρος της έρευνας αφορά το μικροβίωμα του γαστρεντερικού συστήματος.
Το εντερικό μικροβίωμα περιέχει δεκάδες τρισεκατομμύρια μικροοργανισμών, συμπεριλαμβανομένων τουλάχιστον 1.000 διαφορετικών ειδών γνωστών βακτηρίων. Το ένα τρίτο του εντερικού μικροβιώματος είναι κοινό για τους περισσότερους ανθρώπους, ενώ τα δύο τρίτα είναι συγκεκριμένα για κάθε άνθρωπο.
Οι επιστήμονες υποπτεύονται εδώ και χρόνια ότι υπάρχουν συγκεκριμένα μικρόβια και στον ιστό του στήθους και παίζουν ρόλο στην ανάπτυξη του καρκίνου, αλλά μέχρι σήμερα δεν είχαν βρεθεί σημαντικά ευρήματα. Για πρώτη φορά, ερευνητές από το ινστιτούτο της Cleveland Clinic ανακάλυψαν ότι ο υγιής ιστός στο στήθος περιέχει κυρίως βακτήρια της ομάδας Μεθυλοβακτήρια.
«Η ελπίδα μας είναι να βρούμε ένα βιοδείκτη, ο οποίος θα μας βοηθήσει να κάνουμε διάγνωση του καρκίνου του μαστού πιο γρήγορα και εύκολα. Και το πιο τρελό μας όνειρο θα ήταν να να χρησιμοποιούμε αντιβιοτικά ή προβιοτικά για να εμποδίσουμε την ανάπτυξη του καρκίνου», τονίζει ο Charis Eng, πρόεδρος του Cleveland Clinic’s Genomic Medicine Institute.

Comments (0)